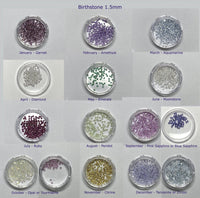

This Solid 14K Gold Shaker Locket Pendant adds a touch of luxurious charm to your look. Expertly crafted with sapphire glass tops and a solid gold frame, this piece features an openable screw top that securely stores whatever treasures you choose to keep close.
♥ The clear glass is made from high quality lab-created sapphire glass, the same kind that is used as luxury watch faces. It ensures superb clarity and durability (hardness of sapphire is a Mohs scale 9), superior to using quartz or other types of glass.
♥ The item measures 35 mm in length, 21.9 mm in width, and stands 6.4 mm thick
♥ The inside dimensions are about 20mm x 3mm thick
♥ Note: The necklace chain is sold separately. You can purchase the solid 14K gold chain as an option, or use one of your existing chains for the pendant.
♥ The gemstones shown in the pictures are not included with this pendant. We can include the gemstones (1ct worth of earth-mined sapphires) for an additional $50.
♥ We also have other birthstones available that we can include (see the last picture). Contact us if you are looking for specific gemstones to go with the locket.